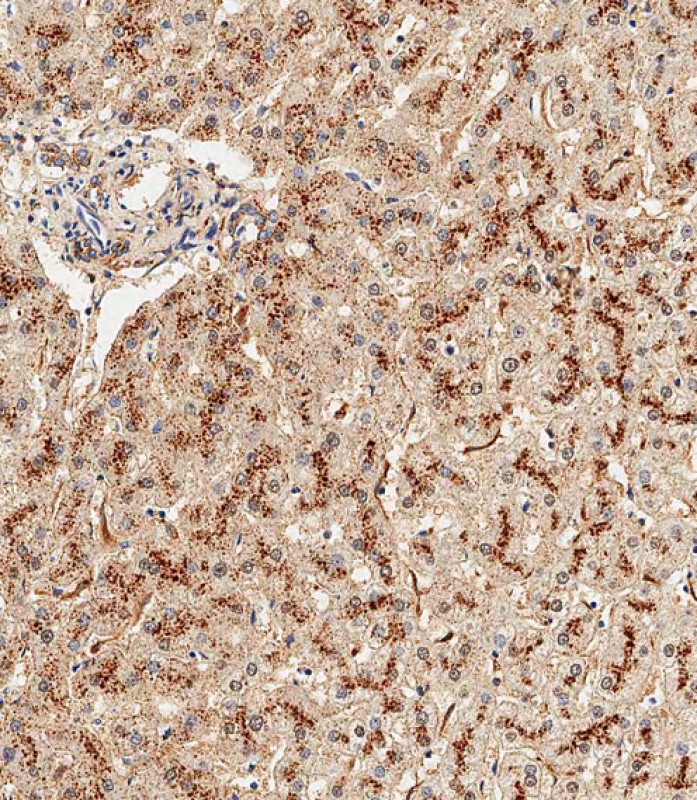

-
分类: 科研抗体货号: P34636别名: PR domain zinc finger protein 12, 211-, PR domain-containing protein 12, PRDM12, PFM9应用: WB反应种属: Human, Mouse
-
分类: 科研抗体货号: P34618别名: Putative protein arginine N-methyltransferase 9, Putative protein arginine N-methyltransferase 10, 211-, PRMT9, PRMT10应用: WB反应种属: Human, Mouse
-
分类: 科研抗体货号: P34635别名: PR domain zinc finger protein 10, 211-, PR domain-containing protein 10, Tristanin, PRDM10, KIAA1231, PFM7, TRIS应用: WB反应种属: Human, Mouse
-
分类: 科研抗体货号: P34647别名: Calcium-binding protein 1, CaBP1, Calbrain, Caldendrin, CABP1应用: WB反应种属: Human, Mouse, Rat
-
分类: 科研抗体货号: P34634别名: Vimentin, VIM应用: WB,IF反应种属: Human, Mouse
-
分类: 科研抗体货号: P34645别名: Class E basic helix-loop-helix protein 41, bHLHe41, Class B basic helix-loop-helix protein 3, bHLHb3, Differentially expressed in chondrocytes protein 2, hDEC2, Enhancer-of-split and hairy-related protein 1, SHARP-1, BHLHE41, BHLHB3, DEC2, SHARP1应用: WB反应种属: Human, Mouse, Rat
-
分类: 科研抗体货号: P34633别名: Protein C-ets-2, ETS2应用: WB,IHC,FCM反应种属: Human
-
分类: 科研抗体货号: P34644别名: Growth factor receptor-bound protein 14, GRB14 adapter protein, GRB14应用: WB,IF,FCM反应种属: Human, Mouse, Rat
-
分类: 科研抗体货号: P34660别名: Lysosomal alpha-glucosidase, Acid maltase, Aglucosidase alfa, 76 kDa lysosomal alpha-glucosidase, 70 kDa lysosomal alpha-glucosidase, GAA应用: WB,IHC反应种属: Human, Mouse, Rat
-
分类: 科研抗体货号: P34643别名: Epithelial membrane protein 1, EMP-1, CL-20, Protein B4B, Tumor-associated membrane protein, EMP1, B4B, TMP应用: WB反应种属: Human

鄂公网安备42018502007531号
鄂公网安备42018502007531号

